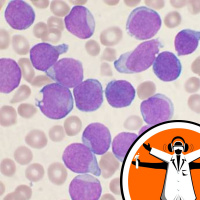
New Leukemia Therapy

Synopsis
Probing the weird, wacky and spectacular, the Naked Scientists Special Editions are special one-off scientific reports, investigations and interviews on cutting-edge topics by the Naked Scientists team.
Episodes
-
Could conspiracy theories be true?
02/02/2016 Duration: 05minScience is full of conspiracy theories, the moon landings were faked and climate change is a hoax, but how many of them are likely to be true? Felicity Bedford spoke to Dr. David Robert Grimes from Oxford University who has given conspiracy theorists the benefit of the doubt and built a mathematical model to test whether, if these conspiracies were real, they would still be a secret... Like this podcast? Please help us by supporting the Naked Scientists
-
Behind the scenes at Call the Midwife
27/01/2016 Duration: 05minCall the Midwife is one of the UK's best loved TV shows, and the new series has just started on the BBC. But as well as its empathetic characters and gripping story-lines, what makes the show special is its attention to detail when it comes to historical and medical accuracy, such as when it tackled the Thalidomide scandal from the late 1950s. Ginny Smith recently had the opportunity to visit the set of Call the Midwife and talk to those who make the show happen, both on and off the screen. She started by asking Executive Producer Dame Pippa Harris about just what it is that makes the show so... Like this podcast? Please help us by supporting the Naked Scientists
-
Free radicals - a miracle cure?
25/01/2016 Duration: 05minHibernating animals put their bodies through huge amounts of stress but seem to remain unharmed. Professor Rob Henning from Groningen University explained to Connie Orbach how mimicking their protective mechanisms might be the key to human health. Like this podcast? Please help us by supporting the Naked Scientists
-
New Leukemia Therapy
18/01/2016 Duration: 05minLeukemia is a cancer of the white blood cells that normally fight infection. About one person in every 200 will develop the disease, a common form of which is called AML, or acute myeloid leukemia. At the moment it tends to have a relatively poor prognosis and over the past 40 years there have been relatively few new treatments for the disease. A bone marrow transplant is often the only chance an individual has. But this week an international team of scientists led by researchers in the UK announced the discovery of a new way to control the disease by blocking the signals that drive the growth... Like this podcast? Please help us by supporting the Naked Scientists
-
National Security Algorithm
18/01/2016 Duration: 05minThe current threat level from terrorism in the UK and many other countries is set to severe, and police and security forces acknowledge that their jobs are being made much harder because today's terrorists have at their disposal a range of communications and social network tools to help them to form alliances, attract new recruits and orchestrate terror campaigns. But, the associations that terrorists make through these channels can also help to identify them, if police are able to screen this sort of data routinely. Most people, though, are justifiably concerned about privacy. Now Michael... Like this podcast? Please help us by supporting the Naked Scientists
-
Why Do Dogs Slurp So Sloppily?
22/12/2015 Duration: 04minDogs drink in a very distinctive way, lapping up water and, more often than not, making a huge mess. But, until now, the exact way they did this has been a mystery. Thankfully, scientists at Virginia Tech wouldn't let sleeping dogs lie and they've worked out the physics behind how dogs drink. Georgia Mills caught up with lead researcher Sunny Jung, who explained how they did it. Like this podcast? Please help us by supporting the Naked Scientists
-
COP21 The Results
21/12/2015 Duration: 05min"195 Nations Set Path to Keep Temperature Rise Well Below 2 Degrees Celsius" were the headlines issuing from Paris in the wake of the Conference of the Parties - or COP21 - meeting. So how will this be achieved, can it be achieved at all, what has the UK signed up to do? Manchester University climate scientist Alice Bows-Larkin was there to hear the verdict... Like this podcast? Please help us by supporting the Naked Scientists
-
Tim Peake Rockets To Space
21/12/2015 Duration: 06minOn Tuesday the UK Space Agency's first official astronaut, Tim Peake embarked on the trip of a lifetime to the International Space Station. The launch was broadcast live on the BBC and watched around the world. Connie Orbach went to join the celebrations at the Science Museum in London... Like this podcast? Please help us by supporting the Naked Scientists
-
Science Breakthrough of the Year 2015
18/12/2015 Duration: 08minWhat was the most momentous bit of science that you heard about this year? Every December the journal Science asks its editorial staff this question and they eventually crown one discovery their "Breakthrough of the Year". Like this podcast? Please help us by supporting the Naked Scientists
-
Plants communicate to trade with fungi
18/12/2015 Duration: 04minA plant protein used to communicate with friendly soil fungi has been identified by Cambridge University scientists. Like this podcast? Please help us by supporting the Naked Scientists
-
ARM: 25 years as Britain's biggest tech company
15/12/2015 Duration: 04minHow an Acorn grew into, amongst other things, an Apple: What began as a business making home microcomputers now turns out the processing brain behind 95% of the world's smartphones. Mike Muller has been at the firm since its inception; he explained to Graihagh Jackson how he and 11 other engineers turned the business into one of the world's largest tech firms... Like this podcast? Please help us by supporting the Naked Scientists
-
Can genetics help you stop smoking?
07/12/2015 Duration: 04minResearchers have linked a gene with your ability to stop smoking, but not all of the scientific community is in agreement... Like this podcast? Please help us by supporting the Naked Scientists
-
Why loneliness can kill
02/12/2015 Duration: 05minPeople with the best social networks, who sing in choirs; play instruments; go to church and take part in team sports, all live longer and tend to be happier, studies have shown. People who feel lonely, or isolated, on the other hand, fare less well and are more prone to ill-health. Now a new study, published this week in the journal PNAS and examining the immune systems of lonely people and monkeys has revealed why this might be. John Capitanio revealed all to Chris Smith... Like this podcast? Please help us by supporting the Naked Scientists
-
Sex addicts hooked by online porn
01/12/2015 Duration: 03minCompulsive sexual behaviour, more commonly known as sex addiction, is driven by the huge novelty provided by online material, a new study has found. Like this podcast? Please help us by supporting the Naked Scientists
-
Supergenes can determine behaviour
27/11/2015 Duration: 03minThe choices we make are often down to past experience and the circumstances, including picking partners. However, for a bird called the ruff, the way it picks up ladies is determined genetically. Some ruffs are territorial and impress using dramatic neck feathers. Less common are the 'girlfriend stealers' who display on the edge of territories and attempt to lure females away. Finally, female mimics or 'cross dressers' approach mates in disguise. Jon Slate from the University of Sheffield explains to Felicity Bedford how genetics played a part in the evolution of these complex behavioural... Like this podcast? Please help us by supporting the Naked Scientists
-
Sounds to make you emotional
13/11/2015 Duration: 04minMusic can have a huge impact on your emotions. Research published this week in PNAS has shown that if you apply the same sound properties that convey emotion in music and voices to environmental sounds such as a car engine they will also make people feel emotional. Daniel Bowling, a neuroscientist from the University of Vienna spoke to Rosalind Davies about what the researchers had done, and what these sound properties are. Like this podcast? Please help us by supporting the Naked Scientists
-
Puberty Timing and Health
13/11/2015 Duration: 05minCan you remember when your voice broke? According to conventional wisdom most men can't, but women have very strong memories of their first period. This means that studies of puberty timing have struggled to investigate effects in men. However, new work from the University of Cambridge has shown that men have much more reliable memories than once thought as Dr Felix Day explained to Connie Orbach. Like this podcast? Please help us by supporting the Naked Scientists
-
How Random are DNA Mutations?
11/11/2015 Duration: 03minCambridge has a rich history of making discoveries about DNA - the genetic code inside each and every one of us. In the 50s Watson and Crick announced that they had unravelled the structure of DNA - the famous double helix shape. Now, 60 years later, another Cambridge scientist - Bill Amos - has made a further DNA discovery - this time about the way the genetic code changes or mutates to allow evolution to happen, as he explained to Graihagh Jackson. Like this podcast? Please help us by supporting the Naked Scientists
-
Cambridge Graphene Technology Day
11/11/2015 Duration: 06minBack in August we did a show all about the super material graphene. At the molecular level, a sheet of graphene looks a bit like chicken wire and is only a single atomic layer thick, if you were to pile up lots of these single layers you'd get graphite, just like the led in a pencil. For the first time in the UK more than 40 companies from around the world came together to show the latest in graphene related technologies. Connie Orbach went along to see what she could find and started by talking to Gaute Juliussen from the graphine production company Graphitene. Like this podcast? Please help us by supporting the Naked Scientists
-
Can we prevent breast cancer?
10/11/2015 Duration: 05minAt the beginning of November, Kat went up to Liverpool for the annual NCRI Cancer Conference, bringing together scientists, doctors, nurses, patients and more from the UK and around the world to talk about the latest progress, ideas and issues in cancer research. On the first night, the charity Breast Cancer Now hosted a heated debate discussing whether after spending so much money investigating the causes of breast cancer as well as treating it, it's now time to focus efforts on preventing the disease in the first place. Sarah Hazell, Senior Research Manager at Breast Cancer Now, gave Kat a... Like this podcast? Please help us by supporting the Naked Scientists